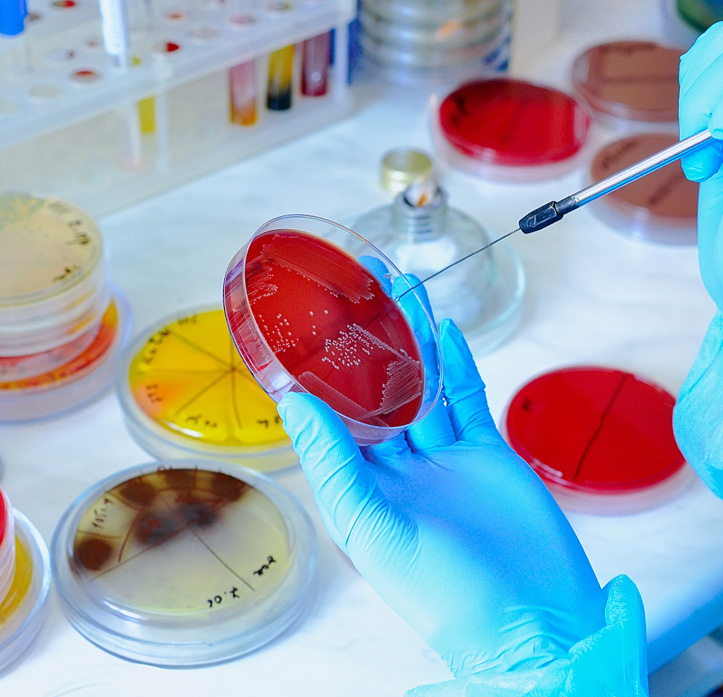

Basic dyes are synthetic dyes that are cationic (positively charged) in nature. They are called "basic" because they are derived from basic (alkaline) compounds. When dissolved in water or alcohol, they release positively charged dye molecules that can easily bond with materials that have negatively charged sites, such as acrylic fibers, wool, silk, and some modified synthetic fibers.